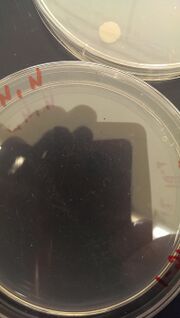
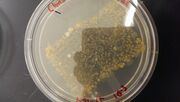

Uploads by Nicholas Carey
From OpenWetWare
Jump to navigationJump to search
This special page shows all uploaded files.
| Date | Name | Thumbnail | Size | Description |
|---|---|---|---|---|
| 00:20, 11 February 2015 | TallGrass2.jpg (file) |  |
119 KB | |
| 00:20, 11 February 2015 | TallGrass1.jpg (file) |  |
146 KB | |
| 00:20, 11 February 2015 | Sporophyte.jpg (file) |  |
50 KB | |
| 00:19, 11 February 2015 | Rose2.jpg (file) |  |
109 KB | |
| 00:19, 11 February 2015 | Rose1.jpg (file) |  |
155 KB | |
| 00:18, 11 February 2015 | HyphaeMaybe.jpeg (file) |  |
21 KB | |
| 00:17, 11 February 2015 | MushroomGills.jpg (file) |  |
79 KB | |
| 00:17, 11 February 2015 | GrassSample2.jpg (file) |  |
121 KB | |
| 00:17, 11 February 2015 | GrassSample1.jpg (file) |  |
168 KB | |
| 00:17, 11 February 2015 | Bush2.jpg (file) |  |
117 KB | |
| 00:16, 11 February 2015 | Bush1.jpg (file) |  |
173 KB | |
| 00:16, 11 February 2015 | Bulb2.jpg (file) |  |
123 KB | |
| 00:16, 11 February 2015 | Bulb1.jpg (file) |  |
192 KB | |
| 05:40, 4 February 2015 | Swab1.jpg (file) |  |
45 KB | |
| 05:39, 4 February 2015 | Swab4.jpg (file) |  |
87 KB | |
| 05:39, 4 February 2015 | Swab3.jpg (file) |  |
67 KB | |
| 05:39, 4 February 2015 | Swab2.jpg (file) |  |
54 KB | |
| 05:38, 4 February 2015 | Swab.jpg (file) |  |
45 KB | 1 |
| 05:37, 4 February 2015 | Plate8.jpg (file) |  |
64 KB | |
| 05:37, 4 February 2015 | Plate7.jpg (file) |  |
53 KB | |
| 05:37, 4 February 2015 | Plate4.jpg (file) |  |
104 KB | |
| 05:36, 4 February 2015 | Plate6.jpg (file) | |
67 KB | |
| 05:36, 4 February 2015 | Plate5.jpg (file) | |
82 KB | |
| 05:35, 4 February 2015 | Plate3.jpg (file) |  |
112 KB | |
| 05:35, 4 February 2015 | Plate1.jpg (file) |  |
81 KB | |
| 05:35, 4 February 2015 | Plate2.jpg (file) |  |
111 KB | |
| 05:33, 4 February 2015 | Gram4.jpg (file) |  |
44 KB | |
| 05:33, 4 February 2015 | Gram3.jpg (file) |  |
62 KB | |
| 05:33, 4 February 2015 | Gram2.jpg (file) |  |
52 KB | |
| 05:32, 4 February 2015 | Gram1.jpg (file) |  |
53 KB | |
| 05:31, 4 February 2015 | Culture2.jpg (file) |  |
54 KB | |
| 05:30, 4 February 2015 | Culture1.jpg (file) |  |
219 KB | |
| 05:56, 28 January 2015 | Stock.jpg (file) |  |
727 KB | |
| 05:55, 28 January 2015 | Side culture.jpg (file) |  |
750 KB | |
| 05:54, 28 January 2015 | Top culture.jpg (file) |  |
803 KB | |
| 05:46, 28 January 2015 | Paramecium.jpg (file) |  |
789 KB | |
| 04:01, 24 January 2015 | IMAG0136.jpg (file) |  |
802 KB |